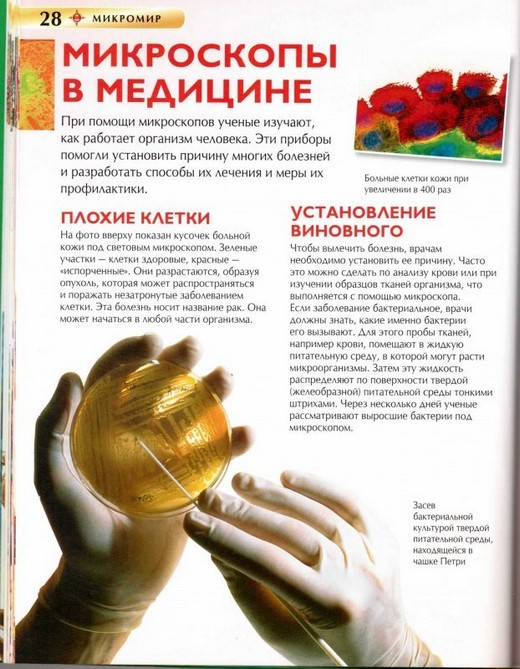

Прошлая цена: 230 руб
Самовывоз из любого магазина
Доставка по городу от 300 руб
Уникальная энциклопедия "Микромир" откроет перед ребенком невероятный мир, который невозможно увидеть невооруженным взглядом. На страницах энциклопедии можно найти огромное количество совершенно невероятных снимков с многократным увеличением микроорганизмов, различных клеточных структур. Помимо этого ребенок сможет узнать больше о самих микроскопах и специальных растворах для них. Прочтя эту увлекательную книгу, ребенок сможет значительно расширить свой словарный запас и повысить уровень эрудиции, получит расширенные знания о мире микроскопических существ.
Масса: 330 г
Размер: 260х205х8 мм
Страниц: 48 (Офсет)
Переплет: Твердый
Купить Детскую энциклопедию Микромир в Новосибирске Вы можете в магазине настольных и развивающих игр "Игры Почемучек"
| Артикул: | 068099 |
| Пол: | Мальчик Девочка |